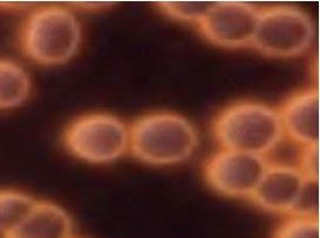

リドルから特別なお知らせ
この度、キャンペーンをご用意いたしました。
ご興味ある方は、是非この期間にお試しくださいませ♡ 特別価格にてご体験いただけます。
ご予約を心よりお待ちしております
Wishpro®とは
『Wishproとは。。。』
肌悩みに合わせて美容成分を選び針や注射を使わずに
磁気を応用した最先端導入技術です。
革新的な肌管理システムと先進的なテクノロジーで特別なアンチエイジング製品を組み合わせることで肌の不調を修正し、若々しく、弾力のある健康的な肌へと導きます。
三位一体の独自技術
赤血球は、人体の最も重要な酸素と栄養素を運搬する細胞です。日々の疲労やストレスによって、赤血球の活性が低くなりつつ、重なり合う形に変化し、酸素と栄養素の運搬能力は低下します。(連銭形成)
MITは、断続的な磁力波から変換された周期的なエネルギー場を作り、血清中の荷電イオンと反応。連銭形成した赤血球に作用し、分離を促します。その結果、細胞内のATP活性を強化し、血流を改善することで皮膚の新陳代謝を促進させ、皮膚の栄養吸収を改善します。
(1)「MIT」+「テクノロジーヘッド」+「特許美容カプセル」三位一体の合体システム
(2) 上質な天然オイルと美容成分を豊富に配合スマートスポンジカプセル

Wishpro®の原理

Wishpro®使用前
・赤血球がお互いに重なり、コインが連なったような状態になっています。(連銭形成)
・赤血球の表面面積が少なくなり、体内に運ばれるべき酸素や栄養素が減少します。
Wishpro®使用後
・重なっていた赤血球が離れ、より多くの酸素と栄養素を効率よく体の隅々までいきわたります。
・また赤血球の流れがスムーズになることで、毒素や二酸化炭素も効率的に排出されるようになります。→血色の良い顔色に。
肌を傷つけない次世代導入方式

エレクトロポレーション単独よりも皮膚抵抗の影響を受けにくく、導入効果率と到達範囲の均一性が高い方式です。
磁気パレスを併用することで通過経絡の再閉鎖が起こりにくく、成分の皮膚内分布より安定する設計です。
分子量:溶解性、皮膚抵抗の制限を受けにくい導入方式です。
Wishpro®有効性-15分の即効性
◆ハリ
テクノロジーヘッドが肌の深部にアプローチし、コラーゲンやエラスチンの生成をサポート。内側からふっくらとしたハリのある肌へ。
◆ツヤ
ピーリングと美容液カプセルが肌のキメを整え、なめらかで輝くようなツヤ肌へ導きます。
◆もっちり
天然オイルが肌をやわらげながら、美容成分の浸透をサポート。弾むようなもっちり肌へ。
◆しっとり
磁気の力で導入された有効成分が、肌の内側から潤いを満たし、しっとりとした仕上がりに。
◆透明感
磁気の力で血流がスムーズになり、健康的で明るい肌印象へ。
カプセルの紹介/ニキビ・敏感肌

アフターリペア エイジング
主要成分: Abyssine 657®
肌の炎症を抑えて鎮静しながら、 免疫力を高める。

カーミングミルク
主要成分:ヒマワリ種子油 & カレンデュラエキス 99.9%
優れた抗炎症作用があり、 肌を鎮静する。

ダブルモイスチュアAPL
主要成分:① PrimalHyal 300 ② Crystalhyal
潤いを与えながらバリア機能を強化し、 傷ついたお肌を修復する力を高めます。
カプセルの紹介/シワ・たるみ

BTX
主要成分:acetyl hexapeptide-8
表情筋に働きかけ、 副作用なしで表情じわの軽減をサポートし、ハリのあるお肌に導く。

ネオエナジーAPL
主要成分:Neodermyl®
肌の土台であるコラーゲン、エラスチン
の新生をサポートする。

ウルトラ エイジ リフティング
主要成分:① Progeline™ ② Tightenyl™
内側から肌を支えるコラーゲン、エラスチン、ヒアルロン酸を土台から強化し、引き締まった弾力のある肌に導く。
カプセルの紹介/毛穴

ピールエクスフォリエーター
主要成分① スイートアーモンドオイル 95%
② Biogomm'age™M (バイオゴマージュ)
古い角質や毛穴の奥の汚れを優しく除去する。
お肌に栄養と透明感を与えます。
カプセルの紹介/乾燥肌・肌荒れ

リジュビネーション シアバター
主要成分:シアバター 99.5%
濃厚なテクスチャーで潤いを与え、
乾燥で傷んだお肌の修復を促しながら保護する。

コラーゲン
主要成分:Mari Coll N-30 (深海魚由来の高純度コラーゲン)
お肌に刺激を与える乾燥などのダメージから肌あれを防ぎ、潤いを与えて免疫機能を高める。

ヒアルロン酸
主要成分:① Crystallheal ② Dunaliella Salina Extract
抗酸化作用があります。 エイジング対策として
糖化からお肌を守り、 免疫力を高める。
カプセルの紹介/くすみ・シミ

深層ブライトニング
主要成分:① β-White™ ② Sea Shine
肌の明るさと透明感を高める。

アンチエイジ ホホバ
主要成分:ホホバ種子油 100%
ホホバオイルは高い抗酸化作用を持ち、アミノ酸やミネラル、ビタミンA、E、Dなど栄養を豊富に含む。

プレミアム エイジ コントゥア
主要成分:① Tightenyl™ ② Neurophroline™
ストレスによる代謝の低下が原因と
なるくすみやクマから肌を守る。
Before/After
wishpro® Price
| Wishproカプセル | 1個 | ¥8,250 |
|---|---|---|
| Wishproカプセル | 2個 | ¥16,500 |
| Wishproカプセル | 3個 | ¥24,750 |
| Wishproカプセル | 4個 | ¥33,000 |











